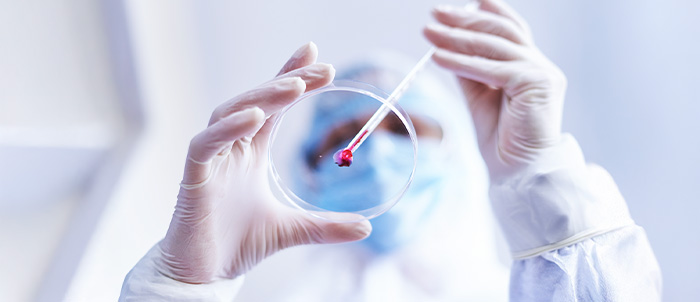

POTOMAC, MARYLAND – August 05, 2025 – IGC Pharma, Inc. (NYSE American: IGC) (“IGC” or the “Company”), a clinical-stage pharmaceutical company leveraging AI to develop innovative treatments for Alzheimer’s and metabolic disorders, today announced encouraging preclinical data on its investigational molecule “IGC-M3”.
The invitro results demonstrates that IGC-M3 may offer disease-modifying potential by targeting multiple biological mechanisms central to Alzheimer’s pathology, including amyloid aggregation, oxidative stress, mitochondrial dysfunction, and neuroinflammation.
- Inhibited aggregation of amyloid a central component in senile plaque formation;
- Promoted disassembly of pre-formed amyloid aggregates, thereby reducing the presence of toxic amyloid species;
- Neutralized reactive oxygen species (ROS) and preserved mitochondrial membrane potential,
- Prevented programmed neuronal cell death by blocking cytochrome c release;
- And reduced pro-inflammatory signaling (e.g., NF-κB and TNF-α) in activated microglial cells.

“These findings suggest that IGC-M3 may be able to intervene at multiple points in the Alzheimer’s cascade, a promising sign for its development as a disease -modifying candidate,”
“Alzheimer’s is a one of the most devastating and costly disease of our time, and patients and caregivers urgently need better options. The early results of IGC-M3 reflect IGC, commitment to develop therapies that can change the course of the disease as well as medications such as IGC-AD1 that help manage symptoms.”

The IGC-M3 molecule is a synthetic derivative featuring a tricyclic aromatic core containing a fused isoindolinone-imide structure. Attached to the nitrogen of the imide is a side chain consisting of a pyridine ring linked via a methylene group to a 1,2,3-triazole ring, a motif often associated with coordination potential and biological activity. Additionally, the molecule bears a benzyl substituent with a phenyl ring substituted by two hydroxyl groups in ortho and para positions, resembling a catechol moiety. This group may contribute polarity, antioxidant potential, and hydrogen bonding capacity. Compound IGC-M3 was synthesized with a yield of 81%, indicating a highly efficient route for the construction of this complex architecture.

In SH-SY5Y human neuronal cells, IGC-M3 showed neuroprotective effects by preserving mitochondrial membrane potential and reducing the production of reactive oxygen species after Aβ42-induced damage. It also prevented the release of cytochrome c, an early marker of apoptosis, and significantly reduced programmed cell death.
In BV2 microglial cells, which mediate neuroinflammatory responses in AD, IGC-M3 reduced Aβ42-induced activation, normalized mechanical cell parameters such as height, stiffness, and adhesion force, and decreased the expression of pro-inflammatory markers including NF-κB and TNF-α, both associated with chronic inflammation in Alzheimer’s disease.

Although these findings are limited to in vitro models, the breadth of biological effects observed suggests that M3 has the potential to modulate multiple pathways in the Alzheimer’s disease cascade. The Company expects that IGC-M3 will advance to in vivo studies to evaluate potential efficacy and safety in animal models. If benefits are confirmed, IGC-M3 could represent a promising candidate for the development of disease-modifying treatments aimed at slowing or halting neurodegenerative progression in Alzheimer’s disease.

The development of innovative compounds like IGC-M3 offers renewed hope in the fight against Alzheimer’s, a disease that currently affects millions of individuals and families worldwide. Multifunctional molecules that can act on several pathological fronts at once may represent the next frontier in achieving meaningful clinical progress and improving patient outcomes.
About IGC Pharma (dba IGC):
IGC Pharma (NYSE American: IGC) is a clinical-stage biotechnology company leveraging AI to develop innovative treatments for Alzheimer’s and metabolic disorders. Our lead asset, IGC-AD1, is a cannabinoid-based therapy currently in a Phase 2 trial (CALMA) for agitation in Alzheimer’s dementia. Our pipeline includes TGR-63, targeting amyloid plaques, and early-stage programs focused on neurodegeneration, tau proteins, and metabolic dysfunctions. We integrate AI to accelerate drug discovery, optimize clinical trials, and enhance patient targeting. With 30 patent filings and a commitment to innovation, IGC Pharma is advancing breakthrough therapies.
Forward-Looking Statements:
This press release contains forward-looking statements. These forward-looking statements are based largely on IGC Pharma’s expectations and are subject to several risks and uncertainties, certain of which are beyond IGC Pharma’s control. Actual results could differ materially from these forward-looking statements as a result of, among other factors, the Company’s failure or inability to commercialize one or more of the Company’s products or technologies, including the products or formulations described in this release, or failure to obtain regulatory approval for the products or formulations, where required, or government regulations affecting AI or the AI algorithms not working as intended or producing accurate predictions; general economic conditions that are less favorable than expected; the FDA’s general position regarding cannabis- and hemp-based products; and other factors, many of which are discussed in IGC Pharma’s U.S. Securities and Exchange Commission (“SEC”) filings. IGC incorporates by reference its Annual Report on Form 10-K filed with the SEC on June 27, 2025, as if fully incorporated and restated herein. Considering these risks and uncertainties, there can be no assurance that the forward-looking information contained in this release will occur. IGC Pharma, Inc. assumes no obligation to update forward-looking statements contained in this release as the result of new information or future events or developments.
Contact Information
Rosalyn Christian
IMS Investor Relations
igc@imsinvestorrelations.com
(203) 972-9200






